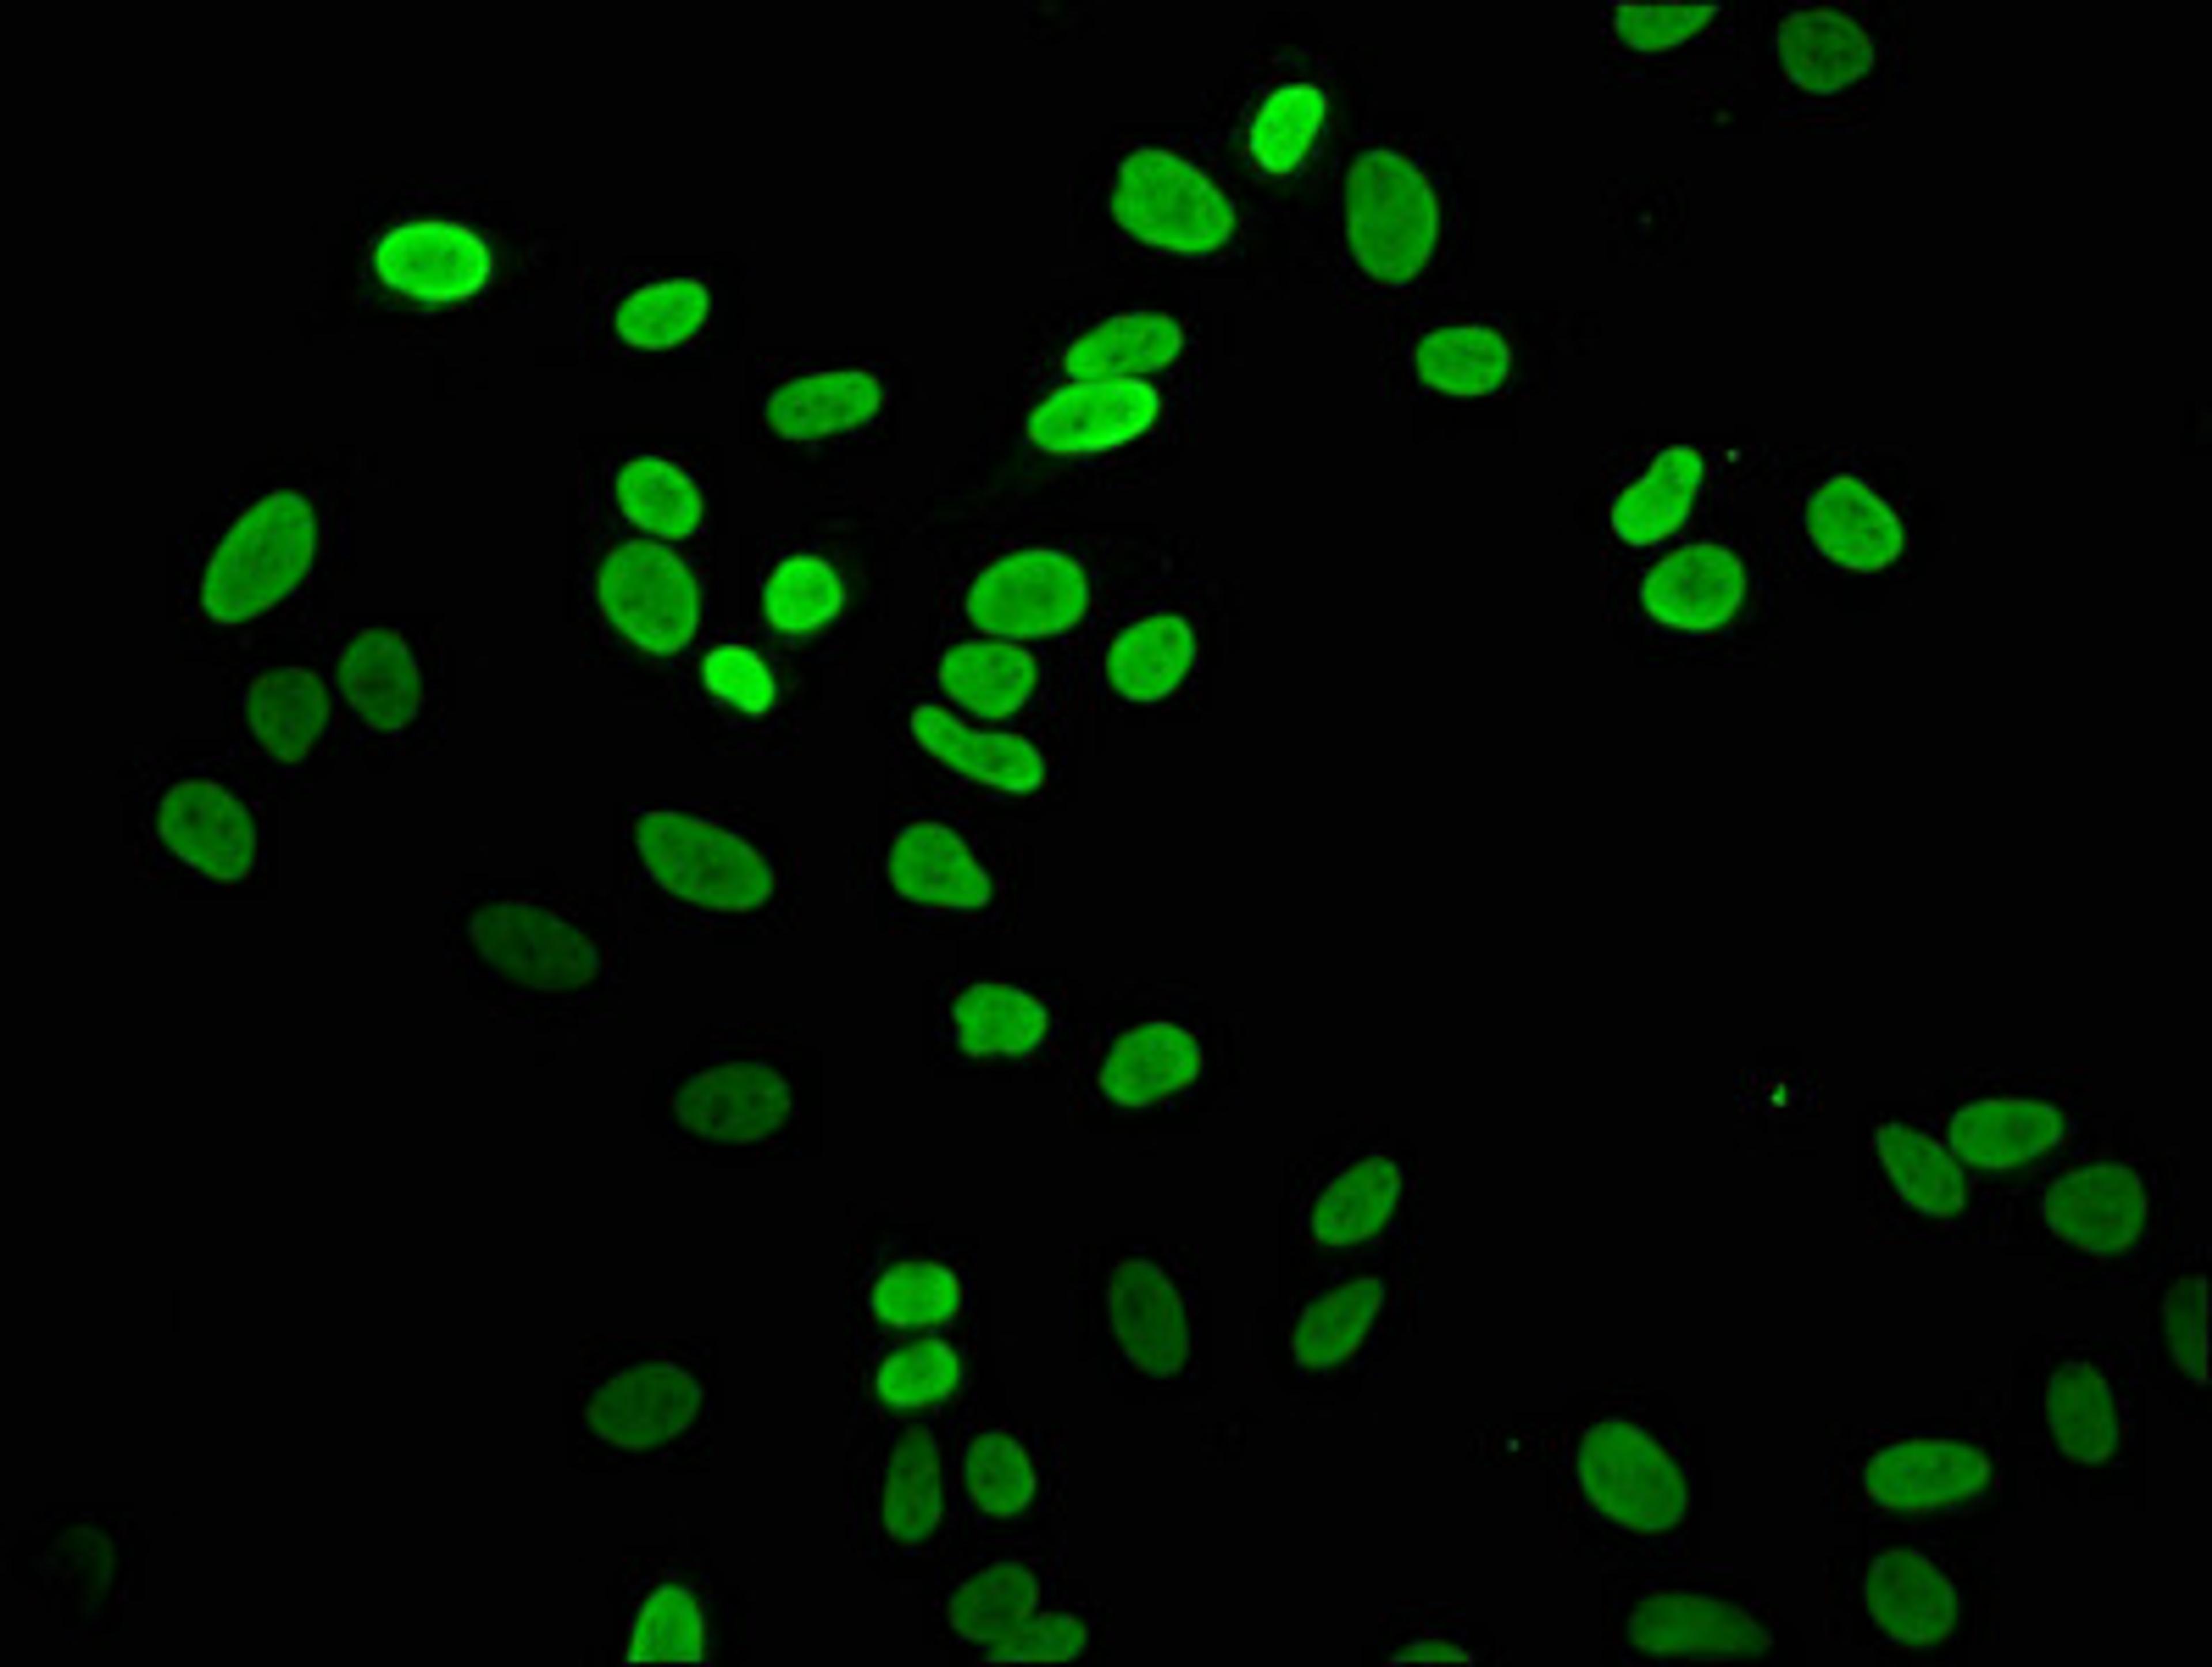
Immunofluorescence staining of Hela cells with CSB-PA010100OA04me1HU at 1:5, counter-stained with DAPI. The cells were fixed in 4% formaldehyde, permeabilized using 0.2% Triton X-100 and blocked in 10% normal Goat Serum. The cells were then incubated with the antibody overnight at 4°C. The secondary antibody was Alexa Fluor 488-congugated AffiniPure Goat Anti-Rabbit IgG(H+L).

Product & ReviewsAntibodies
Mono-methyl-H2AFZ (K4) Antibody
Product Details
- Cat. No.
- CSB-PA010100OA04me1HU
- Type
- Primary Antibody
- Clonality
- Polyclonal
- Host
- Rabbit
Reviews
Applications
- ELISA (ELISA)
- Immunocytochemistry (ICC)
- Immunofluorescence (IF)
- Chromatin Immunoprecipitation (ChIP)